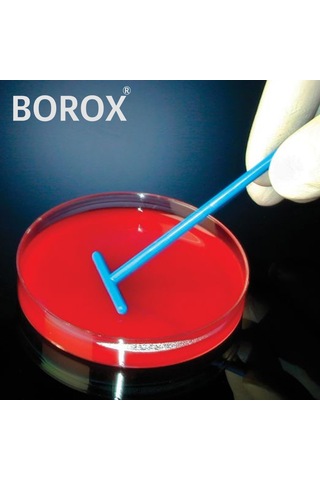
PP Hücre Yayıcı T Şekilli 140 MM Steril Hücre Sıyırıcı 100 Adet

İsolab
için sonuçları listeledik.ÜCRETSİZ KARGO
Lam Taşıma Kutusu-5 Lam-10 lu kutu
(1)
279,63 TL
ÜCRETSİZ KARGO
Balon Dibi Yuvarlak 50 ML 24/29 Şilifli
(2)
198,32 TL
ÜCRETSİZ KARGO
Lam Saklama Kutusu-5 Lam için
170,36 TL
ÜCRETSİZ KARGO
Isolab Porselen Kroze. Uzun Form 35 Mm
 1,000 TL ye %10 indirim
1,000 TL ye %10 indirim214 TL
ÜCRETSİZ KARGO
PP Hücre Yayıcı T Şekilli 140 MM Steril Hücre Sıyırıcı 100 Adet
 1,000 TL ye %10 indirim
1,000 TL ye %10 indirim
950 TL
869,99 TL
ÜCRETSİZ KARGO
İsolab Sigma Potasyum Cloride 12636 1 KG
3.200 TL
SEPETTE
2.880 TL